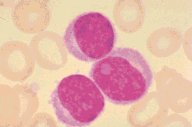

Description
Chronic lymphocytic leukemia: A high oil magnification view of
the Wright's stained peripheral blood shows three leukemic lymphocytes,
one of which has increased nuclear parachromatin and one of which probably
has a nucleolus. However the nuclear chromatin itself is more condensed
than either in lymphoblasts or prolymphocytes.
|
|
Click on this image
to enlarge it, then
on Back buttom
in the Netscape Menu
to shrink it back down



|